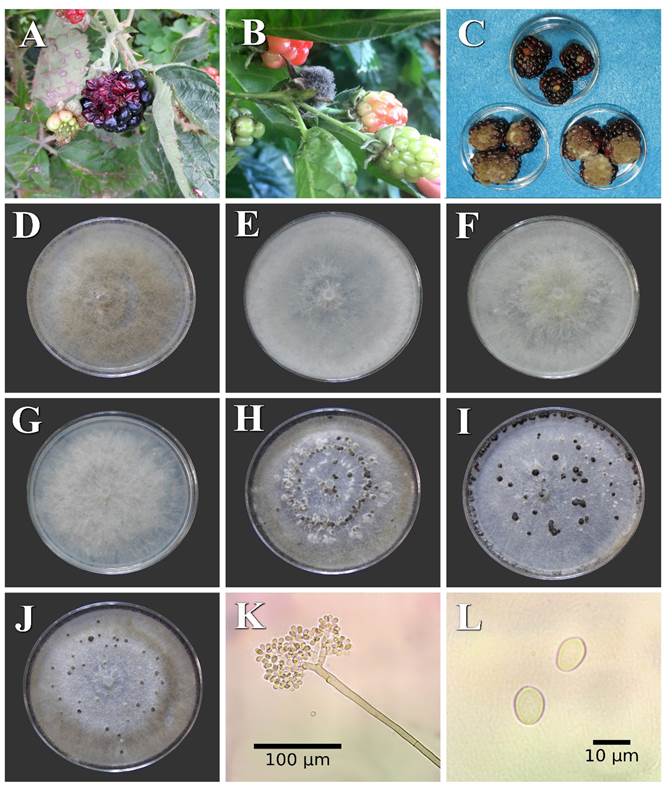

La zarzamora (Rubus sp.) se cultiva en todo el mundo. En México para el año 2017 se reportaron 12, 433 ha sembradas con Rubus sp. con una producción de 266,764 t. Los principales estados productores en orden de importancia son Michoacán, Jalisco, Colima, Baja California y Estado de México (SAGARPA, 2018). Este cultivo es atacado por fitopatógenos y uno de los principales es el género Botrytis, agente causal de la enfermedad conocida como moho gris. Este género incluye cerca de 30 especies descritas (Elad et al., 2014; Ponce de León et al., 2007; Smith et al., 2009) y afecta hojas, tallos, flores y frutos en una amplia gama de cultivos, incluyendo frutas y frutillas como zarzamora, arándano, grosella, frambuesas, fresa y uvas (Droby et al., 2009). La infección por el hongo ocurre en campo y permanece quiescente, durante la postcosecha la infección se activa y se desarrolla la enfermedad durante el almacenamiento, transporte o incluso en el mercado (Calvo et al., 2014; Feliziani y Romanazzi, 2013), ocasionando graves pérdidas (Crisosto et al., 2002; Ippolito y Nigro 2000; Teles et al., 2014).
La infección del hongo Botrytis spp. en plantas de zarzamora se manifiesta como pudrición suave en flores por ser las más susceptibles; en la fruta se observan zonas blandas de color marrón claro que aumentan rápidamente en tamaño hasta secar y momificar el fruto, esto se debe principalmente a que la fruta presenta una vida de anaquel reducida (Droby et al., 2009; Li et al., 2012a). Se han identificado tres especies de Botrytis en frutos de zarzamora: B. patula Sacc y Berl., (Sacc. y Berl.) (Holubová, 1974), B. cinerea Pers.: Fr., (Farr y Rossman, 2011) y B. caroliniana (X. P. Li y Schnabel) (Li et al., 2012a).
Las especies de Botrytis se identifican con base en sus características morfológicas, morfométricas y culturales (Ellis, 1971; Jarvis, 1977), rango de hospedantes y condiciones de crecimiento, donde la morfología del micelio, tamaño y forma de conidios así como número, organización y tamaño de los esclerocios y especificidad de hospedantes son muy importantes para diferenciar especies (Li et al., 2012a; Lorenzini y Zapparoli, 2014; Martínez et al., 2003). El uso de herramientas moleculares se hace imprescindible para complementar la identificación morfológica, por lo que son utilizadas para identificar las especies de Botrytis (Lorenzini y Zapparoli, 2014; Zhang et al., 2010a; Zhang et al., 2010b). El análisis de secuencias en la región del espacio transcrito interno (ITS) es un método eficiente y común para la identificación de hongos (Elmagid et al., 2013) el cual confirma y refuerza la identificación morfológica y se ha utilizado con éxito para identificar a Botrytis cinerea (Aktaruzzaman et al., 2014; Cheon y Jeon, 2013; Nieto et al., 2014; Silva et al., 2016; Zhang et al., 2014; Yu et al., 2014).
En este contexto, el objetivo de la presente investigación fue realizar la identificación morfológica, patogénica, cultural y molecular de aislamientos de Botrytis spp. en el cultivo de zarzamora.
Materiales y métodos
Colecta de muestras y aislamiento de Botrytis sp. En los meses de noviembre y diciembre de 2016 y con base en un muestreo al azar (Steel et al., 1997) se colectaron frutos de zarzamora con síntomas de moho gris en plantaciones comerciales de 17 municipios distribuidos en cinco estados de México (Cuadro 1). Cada fruto se colocó en una bolsa de polietileno individual, se sellaron y se transportaron en frio en una hielera al laboratorio donde se almacenaron a 4 °C (Li et al., 2012a). Posteriormente, las frutillas se colocaron en bolsas de polietileno que contenían toallas de papel estériles humedecidas a temperatura de 20 ± 1 °C y una humedad relativa cercana al 100% (técnica de cámara húmeda) para estimular su esporulación, una vez esporulados los conidios se rasparon, sin tocar la fruta utilizando una aguja de disección estéril, se suspendieron en 1 mL de agua destilada estéril y se ajustaron a una concentración de conidios de 1 × 106 esporas mL-1 (Li et al., 2012a). Posteriormente 200 µL de las suspensiones fueron sembradas en medio de cultivo PDA (Papa Dextrosa Agar) (Bioxon, PDA, 39 g L-1 de agua) modificado con ácido láctico (0.1 % v / v) en cajas Petri, que fueron selladas con Parafilm (Sigma-Aldrich) e incubadas a 20 ± 1 °C, en oscuridad, durante 36 h. Los conidios germinados se purificaron mediante el método de conidio monosporico en cajas Petri con medio de cultivo PDA (Li et al., 2012a)
Pruebas de patogenicidad. Los 211 cultivos monospóricos de Botrytis sp. se inocularon en frutos de zarzamora variedad Tupi en estado de madurez fisiológica, los cuales se lavaron con agua corriente y se desinfestaron en hipoclorito de sodio al 2% por 3 min, se enjuagaron dos veces con agua destilada estéril y el exceso de humedad fue eliminado. El procedimiento de inoculación consistió en la realización de una herida (con aguja de disección estéril a 3 mm de profundidad) y sin herida, al colocar un alícuota de 20 µL de una suspensión de conidios a una concentración de 1 × 105 esporas mL-1 sobre las frutas, por cada aislamiento se utilizaron dos frutos testigos donde se colocó 20 µL de agua destilada estéril (Saito et al., 2016; Zhou et al., 2014). Los frutos inoculados y los testigos se colocaron en recipientes de plástico de 15 × 15 cm que contenían toallas de papel estériles humedecidas con agua destilada estéril sellados para aumentar la humedad relativa y se incubaron a 20 ± 1 °C en oscuridad bajo un diseño experimental completamente al azar inoculando un fruto por aislamiento con cuatro repeticiones con sus respectivos testigos, donde cada aislamiento monospórico fue considerado como un tratamiento. Se midió el diámetro de la lesión cada 24 h finalizando a las 72 h después de la inoculación (hdi). Posteriormente, se realizaron reaislamientos en medio de cultivo PDA para verificar la patogenicidad de los aislamientos inoculados y completar los postulados de Koch, el experimento se realizó dos veces. Se realizó un análisis de varianza y comparación de medias (Diferencia Mínima Significativa) utilizando el programa SAS V.9.1 para Windows.
Cuadro 1 Botrytis cinerea aislado e identificado a partir de frutillas de zarzamora en 17 plantaciones localizadas en cinco estados de México.
| Estado | Origen | Coordenadas geográficas | Número de | Especie de | Número de acceso | ||||
|---|---|---|---|---|---|---|---|---|---|
| (municipio, año) | Altitud (m) | X | Y | Clima | Aislamientos | Botrytis | Clave | del GenBank ITS1 e ITS4 | |
| Colima | Comala, 2016 | 600 | 19.3216 | 103.753 | (A)C(w1) | 12 | B. cinerea | BP3 | MG838558 |
| Cuauhtémoc, 2016 | 940 | 19.3335 | 103.5893 | Aw1 | 12 | B. cinerea | BP5 | MG838559 | |
| Minatitlán, 2016 | 872 | 19.3867 | 104.0571 | Aw2 | 10 | B. cinerea | HAR3 | MG838552 | |
| Jalisco | Mazamitla, 2016 | 2500 | 19.9234 | 103.0078 | C(w1) | 10 | B. cinerea | 2.5 | MG838554 |
| Tuxpan, 2016 | 1487 | 19.5585 | 103.3936 | (A)C(wo) | 10 | B. cinerea | 3.1 | MG838555 | |
| Zapopan, 2016 | 1567 | 20.6724 | 103.416 | C(w1) | 6 | B. cinerea | 4.1 | MG838561 | |
| Zapopan, 2016 | 1567 | 20.6732 | 103.4132 | (A)C(wo) | 6 | B. cinerea | 4.4 | MG838564 | |
| México | Texcoco, 2016 | 2257 | 19.4548 | 98.9096 | BS1kw | 10 | B. cinerea | 1.6 | MG838557 |
| Tenancingo, 2016 | 2020 | 18.9636 | 99.603 | C(w2) | 8 | B. cinerea | T1 | MG838565 | |
| Tenancingo, 2016 | 2020 | 18.9654 | 99.5711 | C(w2) | 7 | B. cinerea | T6 | MG838560 | |
| Michoacán | Los Reyes, 2016 | 1536 | 19.5898 | 102.4548 | (A)C(w1) | 10 | B. cinerea | 5.6 | MG838567 |
| Los Reyes, 2016 | 1536 | 19.5916 | 102.4604 | (A)C(w1) | 10 | B. cinerea | 1.5 | MG838570 | |
| Peribán, 2016 | 1640 | 19.5196 | 102.4237 | (A)C(w1) | 15 | B. cinerea | MF21 | MG838571 | |
| Zamora, 2016 | 1580 | 19.9887 | 102.3039 | (A)C(w1) | 10 | B. cinerea | 4.8 | MG838562 | |
| Ziracuaretiro, 2016 | 1380 | 19.4157 | 101.9035 | (A)C(wo) | 20 | B. cinerea | ZF10 | MG838556 | |
| Zitácuaro, 2016 | 1942 | 19.4332 | 100.3588 | (A)C(wo) | 15 | B. cinerea | MF12 | MG838572 | |
| Morelos | Hueyapan, 2016 | 2340 | 18.8874 | 98.6954 | C(w2) | 10 | B. cinerea | HC19 | MG838563 |
| Ocuituco, 2016 | 1933 | 18.8776 | 98.77393 | (A)C(w2) | 10 | B. cinerea | OS5 | MG838568 | |
| Tetela del volcán, 2016 | 2066 | 18.8935 | 98.7197 | C(w2) | 10 | B. cinerea | OS10 | MG838569 | |
| Tlacotepec, 2016 | 1750 | 19.3883 | 104.0442 | Aw2 | 5 | B. cinerea | HAR4 | MG838553 | |
| Tlacotepec, 2016 | 1750 | 18.8135 | 98.7507 | (A)C(w1) | 5 | B. cinerea | HC25 | MG838566 | |
Caracterización morfométrica, morfológica y cultural. Las variables determinadas a los aislamientos fueron tasa de crecimiento calculada con el crecimiento a las 48 h menos el crecimiento de las 24 h (Zhou et al., 2014), forma de crecimiento y coloración de micelio, días a esporulación, días a formación de esclerocios, número de esclerocios, forma y color de esclerocios (Martínez et al., 2003, Tanovic et al., 2009, Tanovic et al., 2014). Los esclerocios, conidios y conidióforos fueron medidos (n=50) (Li et al., 2012) en un microscopio compuesto OLYMPUS BX 41 con cámara OLIMPUS U-CMAD3 T2, U-TV1X-2 T2 (Tokio, Japón) y la morfometría se realizó con el programa ImageJ (Schindelin et al., 2015). La información obtenida de la caracterización patogénica, morfológica y cultural se utilizó para realizar un agrupamiento por similitud o morfotipos para la identificación de grupos y selección de los aislamientos representativos para realizar la caracterización molecular.
Identificación molecular. Se realizó la extracción de ADN mediante el método Phosphatasa Alcalina (AP) (Ruiz et al., 2014, Sambrook y Russel, 2001). Se amplificaron las regiones del espacio transcrito interno (Internal Trancribed Spacer) utilizando los iniciadores ITS1 / ITS4 (Gardes y Bruns 1993; Staats et al., 2005; White et al., 1990) combinado con el programa de termociclado propuestos por White et al. (1990). Los productos amplificados fueron secuenciados en ambas direcciones con el método de Sanger en la empresa Macrogen (http://dna.macrogen, Corea). Las secuencias resultantes se analizaron por DNASTAR (2001) y Sequencher (2014), y la alineación se realizó con Clustal W en MEGA 6.0 (Tamura et al., 2013). Las secuencias se compararon usando el algoritmo BLAST del NCBI (http://blast.ncbi.nlm. nih.gov/Blast.cgi) y se depositaron en el GenBank.
Resultados
En frutos de zarzamora se observaron síntomas de pudrición blanda de color marrón a negra, sobre las cuales creció abundante micelio, conidióforos y conidios que en conjunto forman el moho gris (Figura 1A y 1B). Se obtuvieron 211 aislamientos de Botrytis sp. aislados de frutos de zarzamora de distintas regiones de México. Las pruebas de patogenicidad confirmaron que el 100% de los aislamientos inoculados produjeron síntomas de moho gris 48 horas después de la inoculación (hdi), en frutos inoculados sin herida como para frutos inoculados con herida, en los frutos testigo no se observaron síntomas o signos del hongo. Al realizar la caracterización morfométrica, morfológica y cultural los 211 aislamientos fueron identificados como Botrytis cinerea (Ellis, 1971; Jarvis, 1977; Martínez et al., 2003). Las zonas productoras estudiadas fueron: Colima, Estado de México, Jalisco, Michoacán y Morelos, de los cuales se obtuvieron 34, 25, 32, 80 y 40 aislamientos, respectivamente (Cuadro 1). El agrupamiento por similitud permitió identificar 21 grupos, de los cuales se seleccionó un aislamiento representativo de cada uno, la descripción patogénica, morfológica y molecular se menciona a continuación.
Pruebas de patogenicidad. De los 21 aislamientos inoculados el 100% fue patogénico en ambos métodos de inoculación, cuando no se realizó herida, los frutos inoculados presentaron síntomas típicos de la enfermedad 48 hdi (Figura 1C), se encontraron diferencias significativas (F = 2762.38, p= ˂0.0001) el diámetro de la lesión varió de 4.2 a 15.9 mm., a las 72 hdi el diámetro de lesión varió de 8.6 a 23.1 mm (F = 8289.98, p = ˂0.0001). En frutos con herida inoculados, los síntomas típicos se manifestaron 48 hdi existiendo diferencias significativas (F = 3551.21, p = ˂0.0001) en el diámetro de lesión el cual osciló de 7.3 a 19.6 mm. A las 72 hdi se mantuvo el comportamiento de los aislamientos, el diámetro de lesión varió de 11.2 a 24.8 mm (F = 4287.86, p = ˂0.0001) en todos los casos el aislamiento MF12 fue el más agresivo ya que indujo mayor diámetro de lesión en comparación con el aislamiento OS10 el cual presentó los menores diámetros de lesión (Cuadro 2). En los frutos testigo no se observaron síntomas o signos del hongo (Figura 1C).
Figura 1 Características morfológicas de B. cinerea A. Fruto de zarzamora con síntomas en campo. B. Fruto de zarzamora con signos en campo. C. Parte superior, frutos de zarzamora inoculados con agua destilada estéril, parte inferior frutos enfermos inoculados con B. cinerea. D, E, F y G. Diferentes formas de crecimiento y coloración de micelio. H, I y J. Forma, color, número y disposición en el medio de cultivo PDA de esclerocios. K. Conidióforo con coni dios. L. Conidios.
Caracterización morfométrica, morfológica y cultural. Los valores de la tasa de crecimiento del micelio varió de 0.7 cm d-1 a 1.5 cm d-1 donde los aislamientos 1.6 y 4.4 crecieron más lento mientras que el aislamiento MF21 fue el más rápido en crecer (Cuadro 3). La forma de crecimiento varió, el 80.95% de los aislamientos formaron micelio superficial y 19.05% formó micelio aéreo, al igual que el color, donde el 42.86% presentó color gris claro, 38.09% exhibió una coloración gris y 19.05% color gris oscuro, (Figura 1 D-G).
Cuadro 2 Diámetro de lesión (mm) ocasionado por B. cinerea en frutos de zar zamora 48 y 72 horas después de la inoculación (hdi).
| Aislamiento | Diámetro (mm) (48 hdi) | Diámetro (mm) (72 hdi) | ||
|---|---|---|---|---|
| Con herida | Sin herida | Con herida | Sin herida | |
| MF21 | 19.6 az | 15.9 a | 24.8 a | 23.1 a |
| 4.8 | 16.1 b | 13.2 d | 20.9 b | 18.1 bc |
| ZF10 | 16.1 b | 13.4 c | 20.1 c | 18.1 b |
| MF12 | 15.9 b | 13.7 b | 19.9 d | 17.9 cd |
| 5.6 | 15.9 b | 13.2 d | 19.7 e | 17.9 d |
| 1.5 | 15.6 c | 13.2 d | 19.7 e | 17.6 e |
| 2.5 | 13.6 d | 10.8 e | 18.6 f | 16.7 f |
| 3.1 | 13.6 d | 10.7 f | 18.6 f | 16.7 f |
| 4.4 | 13.5 d | 10.5 g | 18.5 f | 16.6 f |
| 4.1 | 13.5 d | 10.7 f | 18.5 f | 16.7 f |
| BP3 | 12.4 e | 9.2 h | 17.1 g | 14.6 g |
| HAR3 | 12.4 e | 9.3 h | 16.9 g | 14.3 i |
| BP5 | 12.2 f | 9.2 h | 16.9 g | 14.4 h |
| T6 | 11.9 g | 8.9 i | 15.8 i | 13.0 k |
| 1.6 | 11.9 g | 8.8 j | 15.9 h | 13.1 j |
| T1 | 11.8 g | 9.0 i | 16.0 h | 13.2 j |
| HC25 | 9.9 h | 6.9 k | 13.6 j | 11.1 m |
| OS5 | 9.9 h | 6.9 k | 13.3 k | 10.9 m |
| HC19 | 9.9 h | 6.9 k | 13.6 j | 11.2 l |
| HAR4 | 9.9 h | 7.0 k | 13.4 k | 11.1 m |
| OS10 | 7.3 i | 4.2 l | 11.2 l | 8.6 n |
| Testigo | 0 j | 0 m | 0 m | 0 o |
z Los valores medios seguidos por las mismas letras dentro de la misma columna, son estadísticamente iguales (*= p≤0.05) según la prueba de diferencia mínima sig nificativa (LSD)
Cuadro 3 Tasa de crecimiento y características morfológicas y morfométricas de 21 aislamientos de B. cinerea obtenidos de frutos de zarzamora.
| Esclerocios | Conidios | |||||||
|---|---|---|---|---|---|---|---|---|
| Aislamiento | Crecimiento | Color | Formax | Tamaño | No. por caja | Tamaño | Formay | Tamaño |
| B. cinerea | (cm d-1) | micelio | (mm)z | Conidióforo (µm) | (µm)z | |||
| MF21 | 1.5 | Gris oscuro | I | 1.3- (1.6)- 1.9 × 0.9- (1.3)- 1.6 | 333 | 1163-1795 × 8-17 | E | 6.4-(9.4)- 12.2 × 5.3-(7.0)-8.6 |
| ZF10 | 1.3 | Gris claro | I | 1.8- (2.3)- 3.2 × 1.3- (1.7)- 2.5 | 26 | 957-1393 × 7-16 | R | 7.4-(10.2)-12.7 × 5.7-(8.8)-11.2 |
| HC25 | 1.3 | Gris claro | I | 1.6-(2.3)-3.4 × 1.0-(1.7)- 2.3 | 37 | 948-1404 × 7-16 | A | 7.0-(9.0)- 11.6 × 5.2-(5.9)-6.9 |
| OS5 | 1.2 | Gris claro | I | 1.3-(1.8)- 2.5 × 1.1-(1.4)-2.0 | 115 | 1073-1585 × 8-17 | A | 5.9-(8.5)- 11.0 × 5.2-(6.8)-9.7 |
| OS10 | 1.2 | Gris claro | I | 1.1-(1.9)-2.4 × 0.9-(1.6)- 2.7 | 47 | 1005-1593 × 8-17 | A | 5.6-(8.7)-10.3 × 5.2-(6.5)- 8.0 |
| HAR4 | 1.2 | Gris claro | I | 1.3-(1.9)-2.5 × 0.8-(1.3)-1.8 | 73 | 859-1437 × 7-16 | E | 7.0-(8.5)- 10.2 × 5.3-(6.6)-7.8 |
| 1.5 | 1.1 | Gris oscuro | R | 1.2-(1.6)-1.9 × 0.9-(1.2)-1.4 | 255 | 941-1605 × 8-16 | R | 6.2-(8.5)- 13.4 × 4.7- (6.6)- 9.0 |
| HC19 | 1.1 | Gris claro | I | 0.9-(1.2)-1.3 × 0.6-(0.9)-1.1 | 73 | 1175-1694 × 8-17 | E | 6.2-(8.7)- 10.7 × 5.9-(7.2)-8.6 |
| BP3 | 1.0 | Gris claro | R | 1.3 -(1.9)- 2.5 × 0.8- (1.3)- 1.8 | 86 | 1023-1845 × 8-18 | A | 6.7-(8.1)- 9.6 × 4.9-(6.3)-7.3 |
| T6 | 1.0 | Gris | I | 2.0-(2.8)- 3.6 × 1.5-(2.0)-2.8 | 101 | 1051-1744 × 8-17 | E | 6.9-(8.5)-9.7 × 5.9-(6.8)- 7.8 |
| HAR3 | 0.9 | Gris claro | I | 1.4-(1.7)- 1.9 × 1.1- (1.2)- 1.4 | 128 | 1156-1734 × 8-17 | E | 7.5-(8.8)-10.6 × 5.6-(7.1)- 8.4 |
| MF12 | 0.9 | Gris oscuro | I | 1.6- (2.2)- 3.8 × 1.3-(1.8)- 2.3 | 112 | 1073-1606 × 8-17 | E | 6.7-(8.7)- 10.8 × 5.4-(6.6)-8.5 |
| 5.6 | 0.9 | Gris claro | I | 1.4-(1.8)-2.8 × 1.0-(1.4)-1.8 | 219 | 967-1531 × 8-16 | E | 8.8-(10.4)-13.8 × 6.5-(7.2)- 7.9 |
| T1 | 0.9 | Gris | R | 1.9-(2.3)-3.3 × 1.2-(1.8)-2.5 | 188 | 919-1504 × 8-16 | R | 7.3-(9.0)-10.9 × 5.7-(6.6)-7.4 |
| 4.1 | 0.9 | Gris | I | 1.3-(1.6)- 2.1 × 1.1-(1.3)- 1.7 | 281 | 1053-1682 × 8-17 | E | 6.6-(8.3)-10.8 × 5.5- (6.7)- 8.2 |
| 3.1 | 0.8 | Gris | R | 1.5-(2.0)-2.3- × 1.3-(1.5)-1.7 | 70 | 963-1701 × 8-17 | E | 7.1- (9.1)- 11.9 × 5.6-(6.2)-7.0 |
| BP5 | 0.8 | Gris | R | 1.6-(2.1)-2.5 × 1.2- (1.5)- 1.9 | 113 | 983-1593 × 8-16 | R | 6.4-(8.4)-9.9 × 5.5-(6.7)- 7.8 |
| 2.5 | 0.8 | Gris | I | 2.0-(2.4)-2.7 × 1.5-(2.1)-2.7 | 49 | 846-1492 × 6-15 | E | 6.9- (8.7)- 12.1 × 5.4 -(6.6)- 7.6 |
| 4.8 | 0.8 | Gris oscuro | R | 2.0-(2.2)- 2.6 × 1.3-(1.5)- 1.8 | 76 | 1083-1639 × 8-17 | E | 6.4- (9.4)-12.4 × 5.8- (6.7)- 8.7 |
| 4.4 | 0.7 | Gris | R | 1.5-(2.0)- 2.7 × 1.3-(1.7)-2.3 | 190 | 1023-1740 × 8-17 | E | 6.4-(9.0)- 11.4 × 6.3-(6.9)- 7.27 |
| 1.6 | 0.7 | Gris | I | 2.5-(3.1)-4.0 × 2.0-(2.5)- 3.5 | 143 | 963-1569 × 8-17 | E | 7.2-(8.7)- 11.6 × 5.6- (6.6)-8.3 |
x Código de forma de los esclerocios. R = redondo, I = Irregular.
y Código de forma de los conidios. A = alimonada, E = elíptica, R = redonda.
z Largo × ancho, mínimo-(promedio)-máximo × mínimo-(promedio)-máximo.
El 100% de los aislamientos formaron esclerocios, los aislamientos MF21 y 4.8 fueron más precoces formándolos a los 4 días después de la siembra (dds). En comparación con el aislamiento 4.1 que tardó 11 dds. La forma de los esclerocios varió, 66.67% fueron irregulares y 33.33% redondos (Figura 1 H-J), el número de esclerocios formados por caja Petri fue de 26 (aislamiento ZF10) a 333 (aislamiento MF21) (Cuadro 3) y los esclerocios más grandes los formó el aislamiento 1.6 de un tamaño de 2.5-(3.1)-4 × 2.0-(2.5)- 3.5 mm y el aislamiento HC19 formó los más pequeños de un tamaño de 0.9-(1.2)-1.3 × 0.6-(0.9)-1.1 mm (Cuadro 3).
Todos los aislamientos esporularon, el MF21 y HC19 fueron los más agresivos al esporular 9 dds en comparación con el aislamiento 1.5 que ocurrió 20 dds. Se observaron conidióforos erectos, septados, ramificados, de color marrón a olivo y los más grandes fueron formados por el aislamiento HC19 con un tamaño de 1175-1694 × 8-17 µm mientras que los más cortos los formó el aislamiento 2.5 de 846-1492 × 6-15 µm (Figura 1K). El 61.90% de los aislamientos formó conidios elípticos, 19.05% alimonados y el 19.05% redondos, el 100% fueron hialinos a marrón claro (Figura 1L), los conidios de mayor tamaño fueron los formados por el aislamiento 5.6 de 8.8-(10.4)-13.8 × 6.5-(7.2)- 7.9 µm y los de menor tamaño los formó el aislamiento OS10 de 5.6-(8.7)-10.30 × 5.2-(6.5)- 8.0 µm (Cuadro 3).
Identificación molecular. Los números de acceso de las secuencias ITS obtenidas se mencionan en el Cuadro 1, los acceso de los aislamientos 2.5, 3.1, ZF10, 4.1, 4.8, HC19, 4.4, 5.6, 1.5, MF21 y MF12, presentaron una similitud del 100% con el número de acceso MG907605.1 de B. cinerea; los aislamientos HAR3, HAR4, BP3, BP5 fueron similares (100%) al depósito KX783612.1 de B. cinerea y los aislamientos 1.6, T1 y HC25 presentaron una similitud del 100% con el número de acceso KX463512.1 de B. cinerea, los aislamientos OS5 y OS10 fueron similares al mismo depósito pero en un 99% y el aislamiento T6 fue similar (97%) con el número de acceso KU992695.1 de B. cinerea.
Discusión
Los síntomas observados en la presente investigación fueron típicos de moho gris siendo similares a los reportados por Li et al. (2012a) y Li et al., (2012b). En las pruebas de patogenicidad en el presente estudio el 100% de los aislamientos inoculados fueron infectivos, mostrando síntomas a las 48 hdi. El aislamiento MF21 desarrolló el mayor diámetro de lesión a las 48 y 72 hdi en las dos formas de inoculación alcanzando el mayor diámetro de lesión cuando se realizó una herida, las heridas en la fruta de zarzamora facilitan la entrada de B. cinerea ya que el hongo penetra y utiliza mecanismos como la formación de apresorios, producción de fitotoxinas y secreción de enzimas degradantes de la pared celular (Choquer et al., 2007; Zhang et. al., 2016), de acuerdo a los resultados la presencia de una herida induce mayor diámetro de la lesión, lo cual destaca la importancia de evitar daños físicos durante la cosecha y postcosecha para incrementar la vida de anaquel de la fruta.
Los aislamientos MF21 y ZF10 fueron los que presentaron mayor tasa de crecimiento en medio de cultivo PDA (Cuadro 3) esto se asoció a la agresividad cuando se inocularon en el hospedante, ya que ocasionaron lesiones grandes en poco tiempo, estos aislamientos provienen de parcelas del estado de Michoacán de la región de Peribán y Ziracuaretiro respectivamente, las cuales presentan antecedentes de una aplicación intensiva de productos, en comparación con el aislamiento 1.6 de Texcoco Edo. de México, que mostró una menor tasa de crecimiento y agresividad, a esta plantación de zarzamora no se han aplicado fungicidas. Los datos de crecimiento de micelio encontrados en la presente investigación coinciden con lo reportado por Li et al. (2012a).
En este estudio se encontraron diferentes formas de crecimiento así como la coloración del micelio de B. cinerea que coinciden con diferentes investigaciones (Li et al., 2012a; Lorenzini y Zapparoli, 2014; Ozer y Bayraktar, 2014; Tanovic et al. 2014; Zhou et al., 2014;). Los resultados de la presente investigación ponen de manifiesto la alta variabilidad morfológica del patógeno para desarrollarse en medio de cultivo pero al mismo tiempo comparten similitudes entre los miembros de un estado en particular, por ejemplo los 5 aislamientos del estado de Morelos presentaron micelio de color gris claro y los del estado de Jalisco color gris, además se observó que el aislamiento más agresivo formó micelio de coloración más oscuro, esta correlación entre pigmentación y agresividad posiblemente se explique por la mayor presencia de melanina en los conidios de B. cinerea (Doss et al., 2003).
El tamaño de los esclerocios, la forma, el color y la disposición en el medio de cultivo es importante para la identificación morfológica de B. cinerea(Martínez et al., 2003). Los aislamientos obtenidos producen esclerocios que coinciden en tamaño con los reportados por Erper et al. (2015) para B. cinerea en frijol y con los de arándanos y vid (Saito et al., 2016). La forma redonda e irregular, color negro y distribución en el medio de cultivo de la presente investigación coincide con B. cinerea aislado de zarzamora (Li et al., 2012a). El tiempo que tarda el hongo en formar sus esclerocios in vitro así como el número de estos por caja Petri nos da una idea de la sobrevivencia de los aislamientos en campo. Respecto al número de esclerocios por caja Petri el aislamiento MF21 formó una alta cantidad en corto tiempo en comparación con los otros aislamientos, generó el mayor diámetro de lesión y tasa de crecimiento en relación con los demás.
La esporulación de B. cinerea in vitro tiene estrecha relación con la agresividad del mismo, ya que entre más rápido forme sus estructuras de reproducción se puede diseminar y ocasionar epidemias (Carisse et al., 2015). La forma y el color de los conidios encontrados en la presente investigación son similares a los reportados por Aktaruzzaman et al. (2017); Zhou et al. (2014); Lorenzini y Zapparoli (2014) y Xie et al. (2016). El tamaño de los conidióforos difiere con lo reportado para zarzamora por Li et al. (2012a), aunque es la misma especie y hospedante estos reportaron conidióforos más grandes. El tamaño de los conidios es la variable morfométrica más importante para diferenciar entre especies, lo cual nos permitió identificar a B. cinerea aislado de zarzamora, lo encontrado en la presente investigación coincide con lo reportado para B. cinerea pero en otros hospedantes por Ozer y Bayraktar (2014), Rupp et al. (2017), sin embargo difieren con los reportados por Zhou et al. (2014) y Saito et al. (2016) ya que estos informaron mayor tamaño de conidios. Existe similitud de las características biológicas entre los miembros obtenidos de un estado en particular, es decir, los aislamientos de origen geográfico cercano son similares, por ejemplo, la capacidad de inducir enfermedad, agresividad, el color del micelio, forma y morfometría de esclerocios, conidios y conidióforos, entre otras, cada estado comparte origen geográfico y clima el cual es similar en cada sitio de muestreo por estado de donde fueron obtenidos los aislamientos, (Cuadro 1), lo cual hace que existan similitudes biológicas, sin embargo, existen una variabilidad morfológica, morfométrica y patogénica por estados pero que están dentro del rango de lo reportado para B. cinerea, por ejemplo los aislamientos de Michoacán difieren en las características biológicas de los aislamientos de los demás estados.
B. cinerea se ha reportado causando moho gris en zarzamora en Australia, China, Nueva Zelanda, Sudáfrica, Noruega, Estados Unidos, de acuerdo con los registros del USDA (Farr y Rossman, 2011) y en los Estados Unidos, B. cinerea fue reportada solo en especies de Rubus en Alaska, California, Carolina del Norte y Washington (Li et al., 2012a), y en la presente investigación los aislamientos se identificaron como B. cinerea causando el moho gris en diferentes estados de México.
Conclusiones
Todos los aislamientos fueron patogénicos, se identificó variabilidad en las características patogénicas, morfológicas y culturales las cuales están dentro del rango de lo reportado para esta especie, los aislamientos del hongo obtenidos de la fruta de zarzamora en la presente investigación se identificaron como Botrytis cinerea tomando en cuenta las características morfológicas, morfométricas y culturales, confirmado con el análisis de secuencias de la región del espacio transcrito interno (ITS), por lo tanto se reporta a dicho patógeno como agente causal del moho gris en los estados de Colima, Estado de México, Jalisco, Michoacán y Morelos.











 texto en
texto en 


